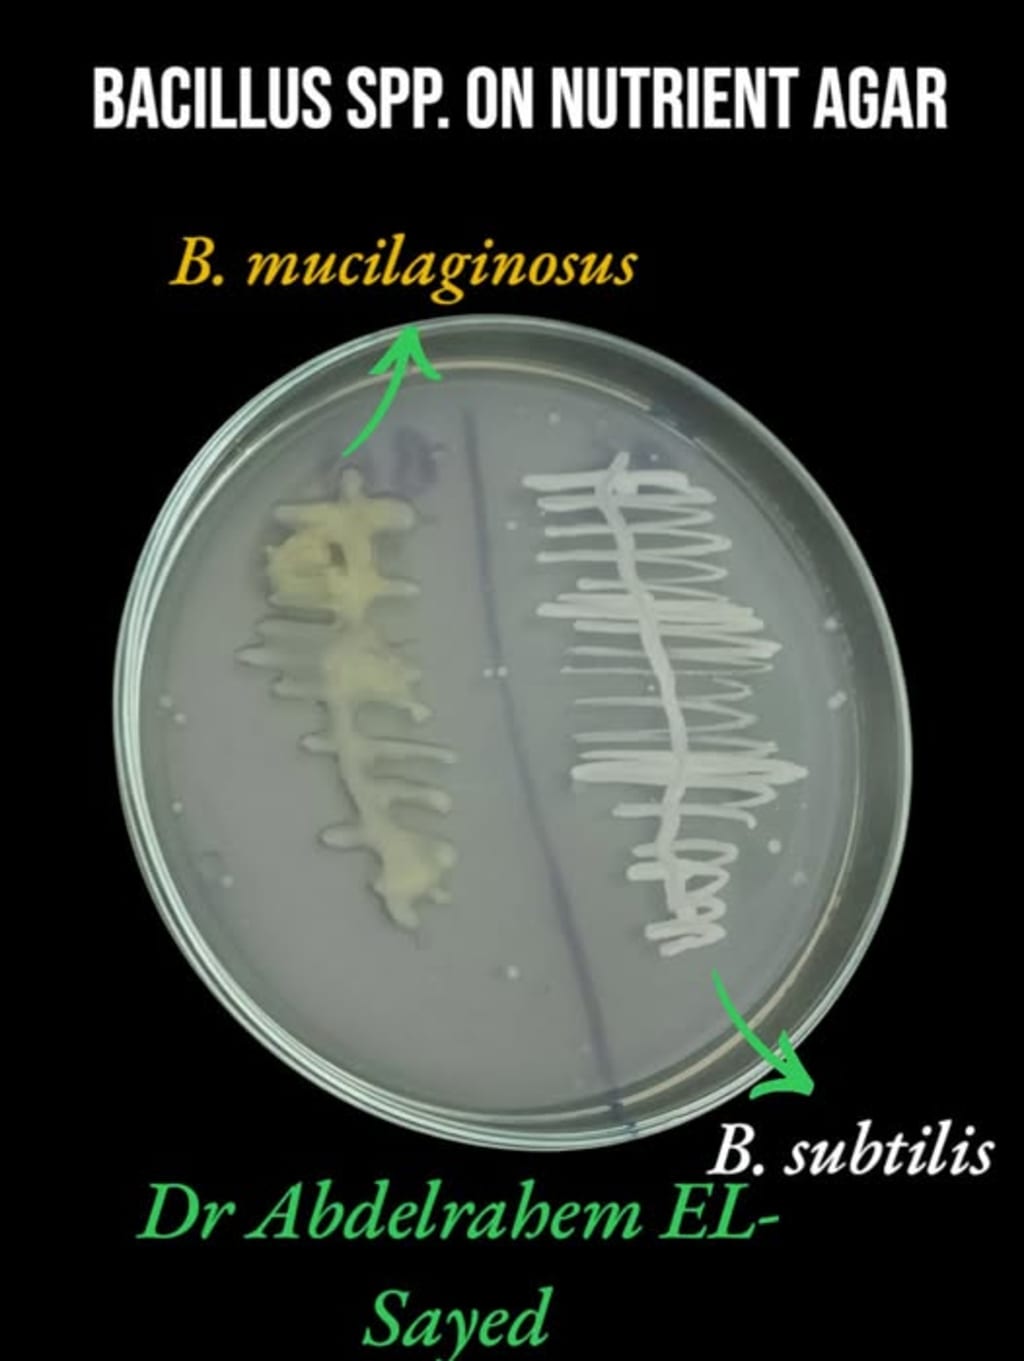

Professional Guide for Isolation, identification and Mass Production of Bacillus subtilis As biofertilizer
Bacillus subtilis As biofertilizer
Professional Guide for Isolation, identification and Mass Production of Bacillus subtilis As biofertilizer
By
Dr Abdelrahem EL-Sayed Abdellatief
PHD in microbiology science
This document provides a clear and practical protocol for the isolation, selection, confirmation, and mass production of Bacillus subtilis for use as a biofertilizer and biocontrol agent in agriculture.
🔬 Introduction
Bacillus subtilis is one of the most important plant growth–promoting rhizobacteria (PGPR) used worldwide as a biofertilizer and biocontrol agent. This Gram-positive, spore-forming bacterium is naturally present in soil and the rhizosphere, where it plays a vital role in nutrient cycling, root stimulation, and suppression of soil-borne pathogens.
The increasing demand for sustainable agriculture and the reduction of chemical fertilizer dependency have positioned Bacillus subtilis as a cornerstone of modern biofertilizer technology. Its ability to form highly resistant endospores ensures long shelf life, environmental stability, and field persistence—making it ideal for commercial production and large-scale agricultural application.
This professional guide provides a comprehensive, step-by-step framework for:
Isolation of Bacillus subtilis from soil and rhizosphere samples using selective and differential techniques.
Morphological, biochemical, and molecular identification for accurate strain confirmation.
Optimization of culture conditions to enhance biomass and spore yield.
Mass production strategies including liquid fermentation and solid-state cultivation.
Formulation development (liquid and carrier-based products).
Quality control standards to ensure viability, purity, and field efficacy.
Storage, shelf-life optimization, and field application guidelines.
Particular emphasis is placed on practical laboratory protocols, cost-effective production methods, contamination control strategies, and industrial scalability. The guide also addresses critical factors influencing biofertilizer performance, including strain selection, sporulation efficiency, carrier compatibility, and environmental stress tolerance.
By integrating microbiological principles with commercial production techniques, this manual is designed to serve researchers, laboratory specialists, biofertilizer producers, and agribusiness entrepreneurs seeking to develop high-quality Bacillus subtilis biofertilizer products that meet modern agricultural standards.
Ultimately, this guide aims to bridge the gap between laboratory isolation and successful field application—transforming a naturally occurring soil bacterium into a reliable, high-performance biofertilizer for sustainable crop production.
🔬 1. Biological Characteristics of B. subtilis
Bacillus subtilis is a Gram-positive Bacilli.
Rod-shaped.
Endospore-forming bacterium.
Commonly found in soil and rhizosphere zone.
🔬 2. Agricultural Importance of B. subtilis
Main agricultural benefits:
Phosphate solubilization
Production of plant growth regulators (e.g., IAA)
Secretion of antifungal metabolites
Enhancement of root development and nutrient uptake
🔬 3. Selective Isolation Protocol
Step 1: Collect rhizosphere soil from healthy plants.

Step 2: Air-dry soil sample for 24 hours.
Step 3: Take 1g of soil in 10 ml dist. and sterilized water, mix well.
Step 3: Apply heat shock at 80°C for 10 minutes and cool immediately to select for spore-forming bacteria.
Step 4: Prepare serial dilutions up to 106.

Step 5: Plate on Nutrient Agar + starch 1% medium.
Add 1 g starch to 100 ml Nutrient agar medium.
mix well and sterilize.
Inoculate the plates with 100 U of soil solution.
incubate at Temp. 30-37 0C for 24 hrs.
Step 6: Select dry, rough colonies and re-streak three times for purity.

🔬 4. Selectivity Enhancement Tips
Heat shock is essential to eliminate non-spore-forming bacteria.
Maintain pH between 7.0 and 7.2.
Use limited nitrogen sources to reduce fast-growing contaminants.
Add mild antifungal agent if fungal contamination occurs.
Prefer non-mucoid colonies to differentiate from related Bacillus species.
🔬 5. Confirmation Tests
Gram staining (positive result expected).
Endospore staining.
Phosphate solubilization halo test.
Dual culture assay against plant pathogenic fungi.
🔬 6. Mass Production Protocol
Suggested liquid medium per liter of water:
o Molasses: 10 g
o Yeast extract: 5 g
o Phosphate source: 1 g
Incubate at 30–35°C with shaking at 150 rpm for 24 hours until reaching approximately 108 CFU/ml.
🔬 7. Storage options
800 ml of liquid medium + 200 ml glycerol 20% at room temperature for 3 – 4 months.
Thanks
Dr Abdelrahem EL-Sayed Abdellateif





Comments (1)
thanks